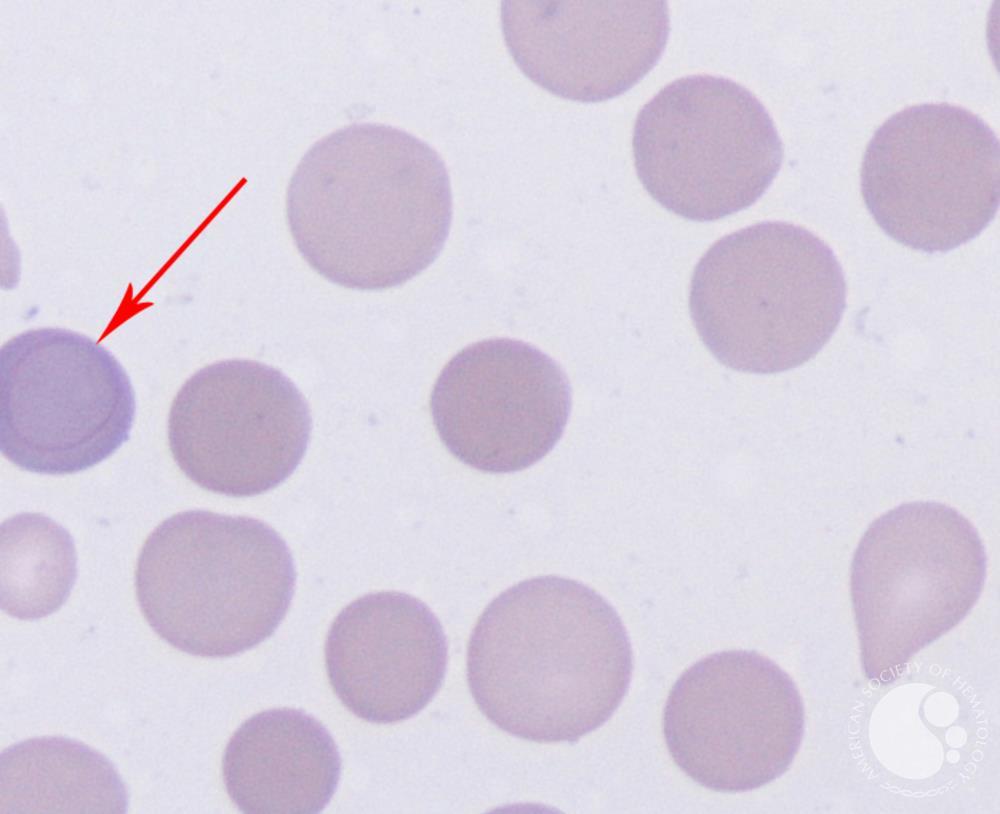
Кольца кебота фото Кольца кебота фото
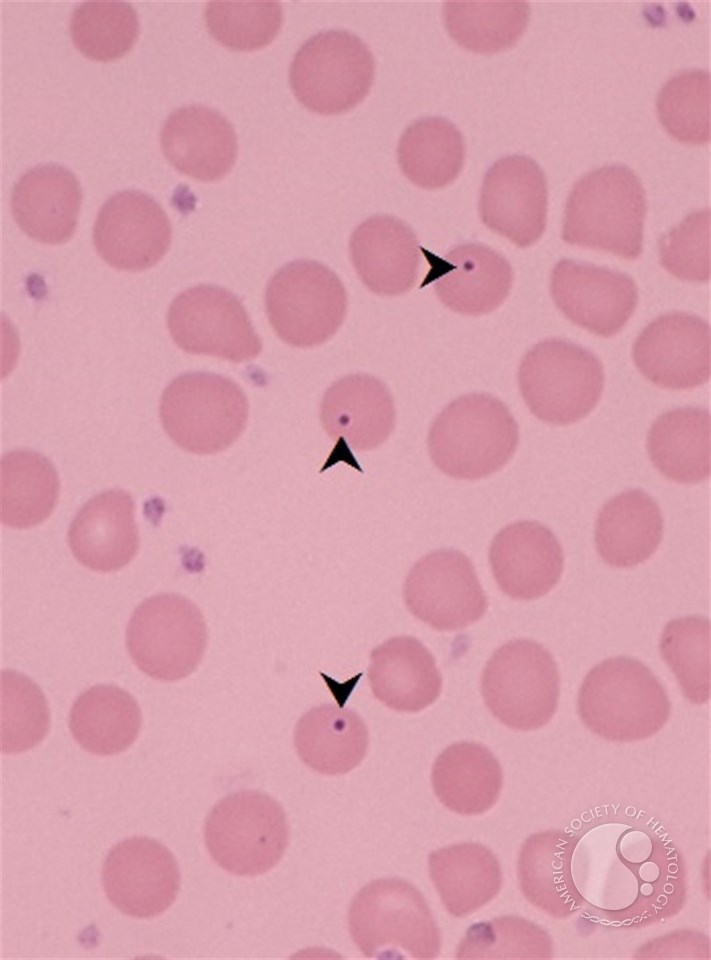
Кольца кебота фото Кольца кебота фото

Смотреть видео: Кольца кебота фото

 Кольца кебота
Кольца кебота
 Кольца кебота - найдено 90 фото
Кольца кебота - найдено 90 фото
 Кольца кебота анемия
Кольца кебота анемия
 Cabots ring Medical laboratory, Medical technology, Blood cells
Cabots ring Medical laboratory, Medical technology, Blood cells
 Free picture: plasmodium vivax, ring, stippling, erythrocyte
Free picture: plasmodium vivax, ring, stippling, erythrocyte
 Howell jolly body Hematology, Medical laboratory, Medical technology labs
Howell jolly body Hematology, Medical laboratory, Medical technology labs
 Тельцами жолли и кольцами кебота
Тельцами жолли и кольцами кебота
 Anel de Cabot / Cabot ring Células sanguíneas, Aneis, Medicina
Anel de Cabot / Cabot ring Células sanguíneas, Aneis, Medicina
 Hematology Final Flashcards Quizlet
Hematology Final Flashcards Quizlet
 Тельце жолли и кольца кебота
Тельце жолли и кольца кебота
 Тельца жолли кольца кебота при какой анемии
Тельца жолли кольца кебота при какой анемии
 Анемия. Острый лейкоз. Хронические лейкозы
Анемия. Острый лейкоз. Хронические лейкозы
 Включения в эритроцитах: тельца Жолли, кольца Кебота, базофильная пунктация, сид
Включения в эритроцитах: тельца Жолли, кольца Кебота, базофильная пунктация, сид
 Кольца кебота - фото 2024 года
Кольца кебота - фото 2024 года
 Фотографии ТЕЛЬЦАМИ ЖОЛЛИ И КОЛЬЦАМИ КЕБОТА
Фотографии ТЕЛЬЦАМИ ЖОЛЛИ И КОЛЬЦАМИ КЕБОТА
 Тельца кебота
Тельца кебота
 Кольца кебота анемия
Кольца кебота анемия
 Кольца кебота - журнал 13malyshok.ru
Кольца кебота - журнал 13malyshok.ru
 Анемии. Морфологические изменения эритроцитов - презентация онлайн
Анемии. Морфологические изменения эритроцитов - презентация онлайн
 Flashcards Table on What Do You Know About Working Of Microscope And Its Uses Fl
Flashcards Table on What Do You Know About Working Of Microscope And Its Uses Fl
 Кольца кебота - фото 2024 года
Кольца кебота - фото 2024 года
 Pin on Blood Cells, Components, and Circulation
Pin on Blood Cells, Components, and Circulation
 Тельца жолли у кошек 58 фото - ZooClever.ru
Тельца жолли у кошек 58 фото - ZooClever.ru
 File:CabotMejo.jpg - Wikimedia Commons
File:CabotMejo.jpg - Wikimedia Commons
 Витамин В12 дефицитная анемия - Reclin
Витамин В12 дефицитная анемия - Reclin
 Тельца кебота
Тельца кебота
 Кольца кебота - журнал 13malyshok.ru
Кольца кебота - журнал 13malyshok.ru
 Basophilic stippling - 1.
Basophilic stippling - 1.
Cabot ring 5
Cabot ring 5
Howell Jolly Bodies in chronic graft vs host disease
Howell Jolly Bodies in chronic graft vs host disease

